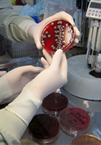
Getting Health Care Right – For All Interested Parties

Journal of Tropical Medicine and Health
ISSN: 2688-6383
Impact Factor: 1.4
perspective
Getting Health Care Right – For All Interested Parties
Stuart Levine*, Arielle Levine
Journal of Tropical Medicine and Healthshort communication

Impact of Urbanization onChagas Disease Transmission in León Brindis, Chiapas
Paz María Salazar Schettino٭, Dolores Guadalupe Vidal López, Javier Vargas Villalpando
Journal of Tropical Medicine and Healthcase report

First Case of Pulmonary Lophomoniasis in Mexico
José Antonio de Diego Cabrera*, Ma. Elena Villagrán Herrera, Ricardo F. Mercado-Curiel, Hebert Luis Hernández-Montiel's, José Martínez-Ibarra
Journal of Tropical Medicine and Health

